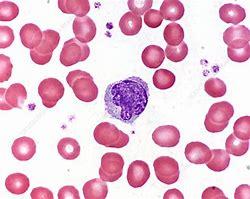

My Blood My Health
Health with Knowledge and



Welcome to My Blood, My Health Digital Magazine
Welcome to the inaugural issue of My Blood, My Health, a digital publication that serves as a beacon of patient advocacy. In this edition, we delve into the intricacies of blood composition and underscore the significance of regular check-ups. A simple blood analysis can often be the first step in detecting serious conditions like cancer, making regular check-ups a crucial part of proactive healthcare.
With this magazine, we aim to pursue Heal Canada's mission to empower patients to access better and equitable services across Canada. We're deeply grateful to our readers for their continued interest and support. Your engagement drives us to bring insightful and valuable content to encourage patient-centricity in healthcare.
If you haven't already, we encourage you to subscribe and stay connected with My Blood, My Health digital magazine for future issues, where we'll continue to explore topics that matter to you and the healthcare community.
Thank you for participating in our journey, and welcome to this enlightening issue!
From your dedicated team



Heal Canada is a registered Not For Profit Organization in Canada healcanadaorg
Disclaimer: The Patient Advocacy Digital Magazine provides general information and resources to promote patient empowerment and awareness. The content is not a substitute for professional medical advice or treatment. Always consult with qualified healthcare professionals for personalized guidance regarding your specific medical condition or situation

The Why! Why My Blood, My Health?
By Cheryl Petruk, caregiverto a myeloproliferative neoplasms (MPN) patient
My journey with myeloproliferative neoplasms (MPNs) began not as a patient but asacaregiver.Whenalovedonewasdiagnosedwithessentialthrombocythemia, which later progressed to myelofibrosis, I found myself navigating a confusing landscapefilledwithmedicaljargonandoverwhelmingemotions.Thisexperience ignited a profound need within me to create something that would empower othercaregiversandpatientsfacingsimilarchallenges.
TheRealityofMPNs
Myeloproliferativeneoplasmsarerarebloodcancersthataffectthebonemarrow's ability to produce blood cells properly. While essential thrombocythemia often causes overproduction of platelets, leading to potential blood clots, myelofibrosis can cause severe scarring in the bone marrow, affecting its ability to produce bloodcells.Bothconditionscarryariskoftransformationintoacuteleukemia.
The journey to an accurate diagnosis and effective treatment plan can be fraught with obstacles As a caregiver, I felt the weight of uncertainty, anxiety, and frustration borne out of the complexities of understanding the disease, accessing reliableinformation,andfindingasupportivecommunity.
CreatingHealCanada
I founded Heal Canada as a beacon of support and guidance in response to these challenges. My vision was to create an organization where people impacted by MPNs could find comprehensive resources, shared experiences, and a community thatunderstoodtheirjourney.Ourprimaryfocuswastoensurethatnoonefacing theserareconditionswouldhavetonavigatethemalone
ExpandingBeyondMPNs
While my journey began with MPNs, I realized that many others were also confronting challenges related to various hematological malignancies Leukemia, lymphoma, multiple myeloma, and other blood cancers present their own set of complex,uniquedifficultiesforpatientsandtheircaregivers.
These challenges often include late diagnosis, specialized treatment plans, and emotionaltollsthatstrainboththepatientsandthosecaringforthem.Recognizing this broader need, Heal Canada expanded its focus beyond just MPNs to provide holistic support for individuals with a range of hematological malignancies. Every journey is unique, but we all share common ground in the need for accessible information,understanding,andconnection.
MyBloodMyHealthProgram
Out of this vision emerged the My Blood My Health program, a central hub where patients and caregivers can connect with accurate information, practical tools, and emotionalsupport.
TheprograminCanadaincludes:
Educational Resources: We curate a collection of educational materials about MPNs, empowering patients and caregivers with knowledge to advocate for bettercareandmakeinformeddecisions.
Support Networks: Connecting patients with their appropriate community for supportandengagement.
Advocacy Initiatives: We tirelessly work to raise awareness about MPNs and other Hematological Malignancies, advocating for better research, treatment options, and healthcare policies that benefit our community. Our aim is to empower, engage and educate patients and their ecosystems, giving them a voiceintheirhealthcarejourney.
AMessageofHopeandEmpowerment
Through Heal Canada and the My Blood My Health program, I hope to transform the caregiver and patient experience from isolation and confusion to empowerment and support. Our journey with MPNs has shown us that while we cannotchangethediagnosis,wecanchoosetofaceitwithcourage,empathy,and adeterminationtomakeadifference.
Together,wecanturnthisjourneyintooneinwhicheverystepbringsusclosertoa worldinwhichMPNsarebetterunderstood,managed,andultimatelycured
Links: Canada(English:https://www.mybloodmyhealth.ca) Canada(French:https://www.monsangmonsante) USA:https://www.mybloodmyhealth.org



A b o u t B l o o d

, b y B r i g i t t e L e o n a r d , P h . D

2m30s
Blood has been a powerful symbol, often associated with vitality and immortality; it has inspired many tales of vampires or quests for the Holy Grail. The legend of Countess Elizabeth Báthory, who is said to have bathed in the blood of virgins to retain her youth, has inspired numerous stories, reflecting our longstanding fascination with the power and mystery of blood. Whether in the chilling narratives of horror films or the mythic quests of fantasy epics, blood continues to captivate our imagination, serving as a potent symbol of the essence of life. By passing through our entire body, the blood nourishes all cells in our organism by providing essential nutrients and oxygen
Medical terms related to blood often begin with hemo-, hemato-, haemo- or haemato- from the Greek word αἷμα (haima) for "blood." Blood accounts for 7% of the total body weight. An average adult contain 5 litres of blood (1). Blood circulates through blood vessels by the heart's pumping action. In animals with lungs, arterial blood carries oxygen from inhaled air to the body's tissues. Venous blood carries carbon dioxide, a waste produced by cells, from the tissues to the lungs, where it will be exhaled
.Four essential components constitute the blood:
Plasma
Red Blood cells (Erythrocytes)
Platelets (Thrombocytes)
White Blood cells (Leukocytes)
Plasma
About 55% of blood is blood plasma, a fluid that is the blood's liquid medium, which is straw-yellow It is an aqueous solution containing 92% water, 8% blood plasma proteins, and trace amounts of other materials. Plasma circulates dissolved nutrients, such as glucose, amino acids, and fatty acids (dissolved in the blood or bound to plasma proteins). It removes waste products like carbon dioxide, urea, and lactic acid.

Red Blood cells are the blood's most abundant cells, representing 45% of the blood volume (hematocrit). Mature RBCs lack a nucleus, giving them a concave shape. RBCs mainly contain hemoglobin, which transports oxygen and carbon dioxide.
Hemoglobin needs iron to work correctly. It is the reason why iron deficiency can cause anemia. It is the hemoglobin that gives the blood its colour red. Blood is bright red when its hemoglobin is linked to oxygen and dark red when it loses oxygen.
Platelets are cell fragments that help your blood clot and control bleeding. They gather at the injured site, attach themselves to the blood vessel, and attract other platelets so they can connect to each other to plug the hole. They also initiate the coagulation process and facilitate wound healing.


White blood cells (WBC) are part of the immune system and help your body fight germs. They include several different types of cells, all of which help protect you from diseases.

Neutrophils constitute 60-70% of the circulating white blood cells They are the first responder when a pathogen is detected; they prevent infections by ingesting and releasing enzymes to destroy invading bacteria and fungi (2).

Monocytes share neutrophils' "vacuum cleaner" function to fight infections, help remove damaged tissues, and destroy cancer cells. Still, they can also present pathogens to lymphocytes to stimulate the immune system's memory, which is essential to improve response over time.
Lymphocytes are much more common in the lymphatic system than in blood. There are three subgroups of lymphocytes.
B cells make antibodies against pathogens to block invasion and facilitate their destruction. T cells destroy cells presenting pathogen molecules and coordinate the immune response. Natural killer cells can destroy infected and cancerous cells that escape T cells.

Eosinophils compose about 2-4% of white blood cells in circulating blood. They primarily deal with parasitic infections. They secrete chemicals that destroy large parasites, such as hookworms and tapeworms, that are too big for any white blood cell to ingest. Eosinophils are also the predominant inflammatory cells in allergic reactions (3).

Basophils the rarest white blood cells (less than 0.5%), are chiefly responsible for allergic response by releasing histamine, which causes the dilation of blood vessels. They also secrete heparin, which inhibits blood clotting Both substances promote the movement of other white blood cells into an area.
B l o o d , t h e o r i g i n
b y B r i g i t t e L e o n a r d , P h . D


2m30s
Blood cells are not eternal. They all have a lifetime specific to them. Some can survive for years to maintain the memory of past pathogens and coordinate a fast and effective attack in case of repeated invasion. However, most survive for a few hours to a few days.
How can we keep the precise amount of each cell needed to face invaders daily? Hidden in our precious bone marrow, we can find the answer. There is hematopoietic stem cells. These stem cells have two beautiful capabilities. First, they can stay immature and multiply themselves until the end of time. Also, they are multipotent; they can transform into all types of blood cells: red blood cells, platelets and white blood cells
Hematopoiesis describes the process of blood cell formation. It's a complex process regulated by many factors within the bone marrow environment. The ability of hematopoietic stem cells to replenish the blood cells throughout an individual's life makes them attractive for research and therapeutic uses in transplants.
During hematopoiesis, cells mature (differentiate) into two groups: myeloid orlymphoid.InFigure1,youcannoticethatthemyeloidprogenitorcellscan mature into platelets and all white blood cells except lymphocytes. Lymphoid progenitor generates lymphocytes: B cells, T cells and natural killer.Youcanalsonoticethatsomematurecellscanbecomeothertypesof cells, like monocytes and B lymphocytes. Monocytes circulate in the blood, and macrophages reside in adult healthy tissues susceptible to pathogen invasion or diseased tissues. Plasma cells are B cells that secrete a large amount of protein called antibodies in response to a pathogen marker calledantigen.
Immune system cells
























If you read about blood cancer, you might have noticed terms such as myeloid cancer, myeloproliferative diseases, or myelodysplasia. These cancers involved cells from the myeloid group Suppose you read about lymphoma or lymphoblastic cancers. These cancers involved cells from the lymphoid group. In the Table, you will find some examples of blood cancer or non-cancer blood disorders involving specific blood cells .
Cells Cancer
Non-Cancer Disease
Plasma cells Multiple Myeloma, Waldenstrom magroglobulinemia Primary amyloidosis
B cells
T cells
Chronic lymphocytic leukemia (CLL), acute lymphoblastic leukemia (ALL), Hodgkin’s and non-hodgkin’s lymphoma follicular lymphoma, or diffus large b cells lymphomas
Cutaneous T cell lymphoma, Extranodal T cell lymphoma Anaplastic large cell lyphoma
Platelets Essential thrombocythemia
Red blood cells Polycythemia vera
Autoimmune diseases: multiple sclerosis, lupus, scleoderma, rheumatoid arthritis
T cell deficiency: severe combined immunode ficiency, AIDS, Omenn syndrome
Immune
Thrombocytopenia (ITP), Gaucher’s disease, Bernard-soulier syndrome, Gray Platelet syndrome, Wiskott-Aldrich sybdrome
Anemia, Sickle-cell disease, Thalassemia,

W h a t I s a
C B C ?
b y B r i g i t t e L e o n a r d , P h . D

1m30s
Doctors can ask for a complete blood count (CBC) to monitor general health during annual checkups or to explore possible causes for symptoms. CBC is a set of tests that provide information about a person's blood cells.
CBC is often used to screen for diseases because changes in many organs may affect the blood. Blood count can also help to assess the impact of some medications. It is also done before surgical procedures to minimize complications. Because of the amount of information it provides, the CBC is one of the most commonly performed medical tests. This test is simple and harmless for patients, and the automatization makes it fast and cheap.
The CBC measures the amounts of white blood cells, red blood cells and platelets. The CBC also measures the hemoglobin and hematocrit values. Additional red blood cell indices MCV, MCH and MCHC which describe the size of red blood cells and their hemoglobin content, are reported along with the red blood cell distribution width (RDW), which measures the variation in the sizes of red blood cells.
Doctors can also request a white blood cell differential analysis, which counts all white blood cells by type This test can also include a count of immature red blood cells (reticulocytes).
Abnormal values will fall below or higher than the reference ranges. The reference range varies depending on your age, sex, and how high above sea level you live. Each parameter of the CBC can indicate a possible issue that needs further investigation In Table 1, you can see few examples of possible causes.
Table 1
150000 to 450000
WBC 4500 to 11000
RBC
Hematocrit
Hemoglobin
M: 4.5 to 5.9
W: 4.1 to 5.1
M: 41.5% to 50.4%
W: 35.9% to 44.6%
M: 14 to 17.5
W: 12.3 to 15.3
CMV 80 to 96
Thrombocytopenia (tone of causes)
Leucopenia (Infection, Bone marrow disease)
Anemia
Iron deficiency
Anemia, Hyperhydratation
Iron deficiency, Thalassemia
Thrombocytosis (Blood cancer)
Leukocytosis (inflammation, Blood cancer)
Blood cancer
Deshydratation, blood cancer
Deshydratation
Vitamin B12 & Folate deficiency
Combining CBC parameters information can help pinpoint underlying causes and improve diagnoses. For example, low hemoglobin, low hematocrit or low red blood cells indicate anemia. However, anemia can have several underlying causes. The average red blood cell size (MCV) can provide additional information to precise the cause of anemia and direct the intervention. See the example illustrated in Table 2.
Table 2
deficiency, Thalassemia, anemia of chronic disease
Alcoholism, Folate and B12 deficiency, Bone marrow disease
blood loss, Hemolytic anemia, Bone marrow disease



B o n e M a r r o w



Common Myeloid progeniror






Mast cell
T i s s

Stem Cells






Myeloid Dentritic Celll
M y e l o i d C a n c e r s
M y e l o p r o l i f e r a t i v e
n e o p l a s m s

b y B r i g i t t e L e o n a r d , P h . D

2m15s
Myeloproliferative neoplasms (MPN) are a group of rare blood cancers in which the bone marrow produces excess red blood cells, white blood cellsorplatelets;
Myeloreferstothebonemarrow; Proliferativedescribestherapidgrowthofbloodcells;
Neoplasm, a synonym of cancer, describes abnormal and uncontrolled cellgrowth.
The concept of myeloproliferative disease was first proposed in 1951 by the hematologist William Dameshek.[1] MPNs arise when cells of the myeloid lineages in the bone marrow develop mutations which cause themtogrowabnormally.
Although considered rare diseases, diagnoses of MPNs are increasing. The recent identification of mutation as an MPN marker may explain this phenomenon.Betterdiagnosticcapabilities,diseaseunderlyingcauses,and access to more effective treatment development improve disease awareness.
ThediscoveryofMPNs'associationwiththeJAK2markerin2005stimulated thedevelopmentofatargetedtreatmentinrecordtime.Onlysixyearsafter discovering the principal mutation in JAK2, the FDA approved its first JAK2 inhibitor for treating myelofibrosis, a subcategory of MPN. This example proves how recent scientific advancements can positively impact people. If we compare it to CML, the targeted treatment, Gleevec, was approved by the FDA in 2001, 42 years after the discovery of its genetic abnormality in 1959.
Unlike CML cells, which always carry the Philadelphia Chromosome, other MPNs can be caused by different genetic abnormalities, making diagnosis morechallenging.
In the Table 1, you will find some subcategories of MPNs and a few of their characteristicsbasedonlatestWHOpublication:[2])
Chronic myeloid leukemia CML Philadelphia Chromosome t(9;22)
High neutrophils, eosinophils and basophils count

3m30s
Myelofibrosis is a rare cancer with abnormal blood cell production. The cause is a mutation in myeloid progenitors in the bone marrow. In the initial phase of the disease, the mutation creates an uncontrolled activation and production of blood cells. It also causes abnormal inflammation, favouring scarring. The progression of scar tissue in the bone marrow further disrupts blood cell production by forcing their migration into the spleen This migration causes an enlarged spleen, aggravating anemia and abnormal blood cell production. Like all cancers, progression is inevitable and characterized by more blood problems. When adequately treated, patients realize all symptoms linked to the disease instead of old age.
In the picture below, you see what pathologists see under the microscope when they observe coloured myelofibrotic bone marrow samples. To compare, you can find a normal sample in the little square at the bottom of the picture. In the first picture, the number of cells is abnormal; a typical picture will have more white bubbles (fat) and fewer pink-purple dots (cells). The second picture's dark lines represent fibrosis that shouldn't be as abundant. The third picture, blue, represents collagen that should be less abundant, too.



The three hallmarks of myelofibrosis are:
1- Enlarged spleen
2- Symptoms
3- Anemia and low platelet levels
What does living with myelofibrosis mean?
Exhausting symptoms and poor quality of life characterize myelofibrosis, impacting severely patients' work abilities and social lives. Some symptoms are associated with inflammation, while others with an enlarged spleen. Unexplained fever, night sweats and weight loss are associated with shortened survival.
Fatigue, pain and depression are some of the most frequent and bothersome symptoms It is easy to underestimate fatigue. Everybody is tired these days. We work too much, are stressed, sleep too little, etc. However, for patients with myelofibrosis, the fatigue is profound due to two significant reasons: anemia and inflammation. Anemia is well known to be linked with fatigue. However, what needs to be understood is that the constant production of inflammation messengers burns out the immune and neurologic systems. Depression: having cancer can make everyone depressed. However, in myelofibrosis, the depression is physiologic due to the inflammation messengers.
When patients receive a treatment that stops the production of these messengers, most of their symptoms significantly improve, including pain and depression. Fatigue also improves even in patients who remain anemic.
How will patients be treated in 2024?
Most patients carry a mutation involving a central activation pathway called JAK-STAT Knowing the type of mutation involved is essential to predicting treatment response and influencing treatment recommendations. Since 2012, Jakavi (ruxolitinib) has been available in Canada to treat patients with myelofibrosis. Jakavi acts as a JAK inhibitor. It was the first treatment specifically targeting the culprit, revolutionizing the treatment paradigm of myelofibrosis. Since then, another JAK inhibitor, Inrebic (fedratinib), has been approved, offering more options to patients.
Most patients treated with JAK inhibitors see their spleen size reduced rapidly.
The image beside shows a patient before ruxolitinib treatment and after 72 weeks. The spleen reduced from 319 to 127 millimetres.

Most patients also experienced an improvement in most of their symptoms, regaining their lives
In the figure beside, you can see that all green bars represent a patient treated with ruxolitinib, and all grey bars represent a patient on the placebo. While most placebo patients have symptoms worsening, most ruxolitinib patients have symptoms improving.

Under the medications, most aspects of their lives improved: global, physical, social, emotional, and cognitive. Jakavi has been used for over a decade; it is becoming apparent that it can also prolong survival.
Current treatment limitations. Anemia and low platelet numbers limit the utilization of JAK inhibitors because they cause anemia and reduced platelet levels as a secondary effect. Doctors can be reluctant to prescribe them if the patients have low hemoglobin levels because anemia and blood transfusions seriously impact survival and patients' quality of life. Even mild anemia reduces life expectancy by half, from eight years to four. Also, to minimize secondary effects, doctors might use smaller doses of Jakavi, impacting the treatment efficacy.
More options are on the way
There is hope for more advanced patients. Two additional JAK inhibitors are now available in the USA: Ojjara (momelotinib) and Vonjo (pacritinib). Ojjara can overcome issues with patients experiencing anemia. If patients have low platelet levels, Vonjo can be the JAK inhibitor of choice.
Ojjara inhibits the JAK like the others. However, it inhibits another molecule linked to anemia in myelofibrosis: ACVR1. Ojjara's unique property allows better control over the disease. Compared to other Jak inhibitors, patients treated with Ojjara will experience significant symptom improvement and spleen size reduction. However, as a bonus, most will improve their anemia status and become transfusion-independent. Becoming transfusionindependent significantly enhances the quality of life. More importantly, improving anemic status with Ojjarra treatment is associated with better survival. GSK submitted momelotinib (Ojjarra) dossier for revision to Health Canada. Health Canada should provide a final decision in 2024. If momelotinib is approved, the mane might have to be different than Ojjara. Also, CADTH invites patients with myelofibrosis to share their experience with the disease and the drug This exercise is essential to provide a patientcentric view of unmet medical needs.
If you want to share your story and support CADTH submission, please contact us at admin@healcanada.org


2m31s
Systemic mastocytosis (SM) is a rare cancer caused by the excessive proliferation of abnormal mast cells.
Typical mast cells are involved in immune reactions against allergens. When activated, they release histamine and heparin into their surroundings, creating inflammation and allergic reactions. Histamine mechanism of action can explain most physicological reactions like swelling, itching, and pain during an allergic reaction.

Due to the mast cell's mechanism of action, physicians prescribe antihistaminic products to manage SM symptoms. These products are helpful. However, patients must continuously take them at higher doses than recommended for an extended period. Most patients are concerned about the long-term impact of this medication, which only manages symptoms without treating the cancer per se.
Before 2016, medical experts classified SM as an MPN. Even though it is now considered a different entity, SM shares several features with other MPNs, such as debilitating symptoms and poor quality of life. Like MPNs, SM tremendously impacts patients' work abilities and social lives.
Common symptoms include:
Fatigue*
Neurological:
Headache, brain fog*, sleeping difficulty, anxiety, and depression.
Ear/Nose/Throat/Respiratory:
Nasal itching & congestion, throat itching & swelling, Wheezing & shortness of breath
SKIN:
Flushing, itching, hives and swelling
Cardiovascular:
Light-headed, chest pain, rapid heartbeat, blood pressure changes
Skeletal:
Bone & musculoskeletal pain
Gastrointestinal:
Abdominal pain*, nausea, vomiting, diarrhea* and bloating
Anaphylaxis*

Also, like other cancers, SM is represented by a continuum from indolent to more aggressive forms. The rarity and the variable clinical presentation make SM challenging to diagnose. Patients can spend several years wondering what is wrong with them (See Table 1). SM patients typically consult more than five specialists before getting a precise diagnosis. Misdiagnosis and useless treatment are frequent. In some tragic cases, patients are referred to a psychiatrist.
Patients can progress from indolent forms to more aggressive forms and die from this progression. Life expectancy depends on the form diagnosed. Patients with advanced form have a life expectancy of less than five years. Until recently, the medical community thought that the indolent form of SM had minimal impact on life expectancy. However, more recent studies disprove this belief and shed light on the real impact of this disease on all afflicted patients.
Unlike other MPNs, patients with SM experience frequent and unpredictable anaphylaxic reactions. The unpredictability is a primary concern for most patients. In a recent survey, 64% of patients reported avoiding leaving the house because of SM. (8) This fear is unsurprising when considering what can trigger an event: heat, stress, temperature change, exercise, food and alcohol, medication, odours, cold, and insect stings (1,2).
Patients request treatment that addresses the underlying disease instead of helping manage symptoms. Recently, avapritinib, a new medication for SM, was submitted to Health Canada for approval and to CADTH for public reimbursement.
Avapritinib offers hope to patients with systemic mastocytosis. Under the commercial name Ayvakit, the product has been approved in the United States since 2021 for advanced forms of SM and in 2023 for indolent forms of SM. Avapritinib is a selective inhibitor of a mutation (D816V) in a protein called KIT. The mutation called KITD816V is present in more than 95% of SM patients. Selective and targeted treatments like avapritinib often have a better safety profile compared to traditional chemotherapy
Clinical studies assessing avapritinib in SM were positive, demonstrating that avapritinib is efficient and safe for patients. The results are encouraging because most patients respond to the therapy even if they failed previous treatment. Also, the response is rapid and durable. Avapritinib demonstrated disease-modifier properties and an improvement in most symptoms.
Hopefully, this new medication will be available soon to Canadian SM patients.

N o n - C a n c e r B l o o d
D i s o r d e r s

W h a t i s H e m o c h r o m a t o s i s o r
H e r e d i t a r y H e m o c h r o m a t o s i s ( H H ) ?
b y C a n a d i a n H e m o c h r o m a t o s i s S o c i e t y
Hemochromatosis or Hereditary Hemochromatosis (HH) is a genetic disorder that affects the body's ability to regulate iron absorption. If left untreated, HH can lead to severe consequences, causing an accumulation of iron in various organs and potentially resulting in life-threatening conditions. In Canada, HH is the most common genetic disorder, affecting primarily Caucasians of Northern European descent.
Common Symptoms Include:
Chronic fatigue
Joint pain (bone and joint disease)
Diabetes mellitus
Irregular heartbeat
Family history of early death by heart failure
Cirrhosis
Liver cancer
Weight changes
Bronze or grey skin colour
Hypothyroidism
Infertility
Impotence
Hypogonadism
Depression
Diagnosis

A ferritin blood test could indicate the presence of hemochromatosis, as high ferritin levels in the blood are associated with high iron levels in the body However, routine blood tests may not include checks for ferritin levels; it is therefore imperative to specificallyrequestthistest.Transferrinsaturationratesandserumferritinlevelscanalso suggestpossiblehemochromatosis.
Based on the results of these tests, a physician can provide the requisition for genetic testing,whichcanconfirmorruleoutthediagnosis
GeneticTesting
Genetic testing can confirm or deny gene mutations associated with HH and is, therefore, an efficient tool for diagnosis. However, it is important to remember that genetictestingisapersonaldecisionthatcanhaveimplicationsthatextendbeyondthe individual to the family or to biological relatives. Genetic counselling services are availablebyreferralthroughafamilydoctor
Monitoring,TreatmentandMaintenance
The primary treatment of HH consists of a de-ironing protocol whereby excess iron is removedthroughaprocedureknownasphlebotomy,thedrawingofblood.Intheinitial phase of this protocol, phlebotomies may need to occur once or even twice a week, depending on the amount of stored iron and according to the hematologist's recommendations As levels normalize, phlebotomies may become as infrequent as three or four times a year These can occur at a hospital outpatient clinic or blood donationcentre.
Phlebotomy is a very effective treatment for HH. Studies show that both survival rates and quality of life significantly improve with phlebotomy therapy, even for patients who have already sustained organ damage. For those diagnosed early, before clinical symptomsmanifest,longevityisstatisticallythesameasfortheaveragepersonwithout HH(intheabsenceofotherriskfactorsforliverdisease,suchasalcoholismorhepatitis)
Persons with HH should ask their doctor about the management of complications, screening for liver cancer, avoidance of supplemental iron and appropriate vaccinations forhepatitisAandB.
DonatingBlood
PeoplewithHHwhoareotherwiseeligiblecanbecome regular donors at Canadian Blood Services (CBS) or Héma-Québec Donating blood can be a comfortable solution for lifetime hemochromatosis maintenance andprovidingmuch-neededbloodforotherCanadians.
ChildrenandRisk
It is rare for iron overload to occur in youths. Classic HH iron accumulation is slow, taking 20-30 years to manifest symptoms At the same time, newborns and infantsnaturallyhavehigherironsaturationandferritin levels.
FamilyAwareness

Due to the hereditary nature of HH, encouraging immediate family members to check theirironlevelsisarobustpreventivemeasure.
AbouttheCanadianHemochromatosisSociety(CHS)
Founded by Marie Warder in 1980, the Canadian Hemochromatosis Society is a registerednon-profitcharitablesociety(#119219160RR0001).
CHS's mission is to promote early diagnosis of hemochromatosis by raising public awareness, informing the medical community, and encouraging early screening of atrisk populations. CHS provides support and information to individuals and families affectedbyironoverload
Visitwww.toomuchiron.catolearnmore!
CanadianHemochromatosisSociety
Suite285–7000MinoruBlvd
Richmond,BCCanadaV6Y3Z5
Toll-Free:1-877-223-4766
Email:office@toomuchiron.ca

A l l i a n c e s a n d
C o l l a b b o r a t i o n s

The GMPNSF is one of those things which grew out of nothing.
During the early stage of COVID, we had to stay home for long periods and were not allowed to leave. This was a terrible time, especially when you are continuously used to moving worldwide.
So, I had to occupy myself and analyze what we had in our MPN world: physicians, researchers, patients, pharmacists, caretakers, etc. I analyzed their activities and found that they were all very active, mostly professional, but all worked in their field. There was little or no cooperation or talks between the different groups.
I decided to create a Foundation, which should be a platform where the previously mentioned actors can talk to each other, explain their problems, worries, plans and, most importantly, find solutions. I thought that if we want to improve the quality of life of MPN patients, we have to talk and act more together.
During the first year, it was not always easy to grow the Foundation from zero, but slowly, with small webinars, round tables with patients, and lots of interviews, we started to grow and could explain our idea to all the players. To achieve such growth, you must be patient and understand the different actors' special situations.
The most important thing is to remember that what we do is for the patients, so our activities must be patient-oriented. This is not always easy, but being patient has always been easy.
Last year, in September, the GMPNSF organized our yearly Symposium with patients, physicians, researchers and representatives of the pharma industry in our room, and we acted like a big family. The meetings were very instructive for all parties, and have shown how important it is to talk to each other and touch on topics previously never touched on in combined meetings.
Therefore, the project’s first goal has been achieved, and we will soon have our 4th MPN Spring symposium hybrid in Barcelona. Nearly 50 people will attend the meeting, and we look forward to finalizing some clear agreements and a better mutual understanding.
A lot of work is still waiting for us. New treatments can at least chronicle our illness like it has been possible in CML and mainly to improve quality of life. We still have very life-changing symptoms, like fatigue and itching. So far, no pharma industry has been researching for a remedy against these symptoms, which are a heavy burden for us patients. But also bone pain, night sweats and mental health are acute problems.
The other problem is that not every Hematologist is an MPN specialist. We have a lack of MPN specialists, and this has to be improved. Many family doctors do not know about our illness and do not send possible patients to the Hematologist or MPN specialist.
Analytical data, such as the Allele burden, which is not applied in many countries, need to be further improved.
Despite the challenges, we remain optimistic about the future of MPN care. We believe that in the coming years, we can make significant strides in enhancing the quality of life for MPN patients. We are committed to this cause and will work tirelessly towards it.
For more information about the Global MPN Scientific Foundation, please visit www.gmpnsf.org.


Improving lives of MPNs patients
The Global MPN Scientific Foundation (GMPNSF) is a charitable nonprofit organization dedicated to advancing research and management of MPNs. Our ultimate goal is to raise awareness, facilitate collaboration, and improve the lives of people affected by MPNs.
Our Mission
At Global MPN Scientific Foundation, we understand the challenges and gaps in the current management of MPN, such as:
Lack of awareness and education among patients, physicians, and scientists
Limited access to specialized testing and care
Variability in diagnostic criteria and treatment guidelines
Insufficient data on the natural history and outcomes of MPN
Limited availability of effective therapies and clinical trials
That's why we are committed to providing a source of professionally backed information, building and facilitating an MPN community, and advocating for patients affected by this rare group of blood cancers. Global MPN Scientific Foundation is run by volunteers comprising MPN patients and healthcare professionals who share this vision.
On our platform, you will find a wide range of unbiased and medically backed information, including leaflets, newsletters, and forums where you can meet and hear about the latest MPN research. You will also learn about our investment in research and support for clinical trials. Moreover, you will discover how we are developing links with MPN groups worldwide to become more visible in advocating for MPN patients.
We invite you to join us in our mission to improve the lives of people living with MPN. Whether you are a patient, a physician, or a pharma representative, you will find valuable resources and opportunities to connect with others who share your interest in MPN.
Together, we can make a difference! www.gmpnsf.org.


Created in 2017, the Acute Leukemia Advocates Network (ALAN) is an independent globalnetworkofpatientorganizationsdedicatedtochangingtheoutcomesofpatients withacuteleukemiabystrengtheningpatientadvocacyinthatarea.OurroleatALANis to support our members in supporting patients and their families, raise awareness of leukemia, and conduct work that is best done internationally, like generating data and evidence Allouractivitiesarepatient-led,collaborative,andevidence-based Whoweare?
In March 2024, the network counts 56 member organizations from 52 countries and is governed by a steering committee. All steering committee members are leaders of national patient organizations focusing on leukemia and blood cancers from different regionstoensureglobalrepresentation.
Howdowework?
AtALAN,weareconvincedthat:
A strong collaboration between contributors of a multi-stakeholder project will likely generatebenefitsforallpartiesinvolved
Patients' and patient advocates' perspectives are unique. Therefore, they should be considered specialist knowledge complementary to other experts, academia, and industry.
So, we collaborate on various projects with the pharmaceutical industry, other patient organizations,medicalsocieties,researchers,clinicians,andotherexperts
Whatdowedo?
1-CapacityBuilding:
Asaglobalorganization,partofourworkistosupportourmembersinhelpingpatients and their families in their country. We provide continuous education to them on advocacy, medical, and any other topics relevant to their work via webinars, an online academy,andanadvocatedevelopmentprogram.
We also created a resources center with materials in various formats, ready for use or to be translated, so members can save time and resources creating information for their organization.
2-Raisingawareness:
Theglobalstudyweconductedshowedthat:
85%ofleukemiapatientswhotookpartinthestudyreportedthattheydidnotknow that the symptoms they were experiencing before diagnosis could be symptoms of leukemia
51% of leukemia patients who participated in the study reported that they were diagnosedthroughtestsforsomethingotherthantheirleukemia.
Part of our efforts is to raise awareness of the symptoms of leukemia among the general public ALAN runs a yearly campaign called #BeLeukemiaAware, with peak activity during Blood Cancer Awareness Month (https://bloodcancerawareorg/) and World Leukemia Day (https://frworldleukemiadayorg/) Our message is, "Don't ignore symptoms; early diagnosis saves lives."

3- Evidence-based advocacy:
In 2017, patients with acute leukemia had a poor prognosis (e.g. 5-year OS in AML was less than 20%). Since then, there have been many changes in how acute leukemia is treated, with many new options.
There was a need for a greater understanding of the quality of life, experiences, and preferences of patients with acute leukemia and their families.
ALAN has been running various studies, using validated methodologies and statistical methods to ensure robust evidence
Our work helped to
Understand the quality of life of acute leukemia patients at different points in the patient journey.
Gather information on patients' and their carers' lived experiences and perceptions.
Elicit acute leukemia patients' treatment priorities and preferences for treatment outcomes and characteristics and explore the tradeoffs they are willing to make.
The evidence generated helps us and our members drive conversations with various stakeholders and ensure the voices of acute leukemia patients and their families are heard.



Mission Stateme

Know our Blood seeks to improve health outcomes and quality of life for individuals and families affected by blood disorders in the African/Caribbean community through targeted education, empowerment and advocacy.
Vision Statement
Know our Blood envisions a world where all individuals regardless of ethnicity, have access to equitable, high quality healthcare for blood disorders and thrive in a supportive community.
To Advance Education by providing awareness and informational programs to visible minorities, on the various blood disorders that are genetically prevalent among their ethnicities, like sickle cell disease, thalassemia and anemia.
To Promote Health by encouraging blood and plasma donations among individuals of African descent, through promotions, partnerships and other related activities, to improve the amount of appropriate transfusable blood publicly available to individuals with blood disorders within the African/Caribbean community
To Promote Health by providing individuals and families affected by blood disorders with access to support services and resources for managing and sustaining their health conditions
To Address and Prevent the Challenges of related healthcare access faced by individuals with blood disorders withing the African/Caribbean community by advocating for equitable access to healthcare services, treatments and research opportunites
There are often significant disparities in healthcare access and outcomes within minority communities, including the African/Caribbean population. Educating individuals about inherited blood disorders such as sickle cell disease, thalassemia, and hemophilia and acquired disorders such as multiple myeloma and nonHodgkin’s lymphoma KYB aims to bridge the knowledge gap, enabling these communities to understand their health risks better and access appropriate care
In a bold new initiative to address health disparities within the African and Caribbean communities, Know Your Blood (KYB) has launched its operations as a non-profit organization dedicated to raising awareness about blood disorders and promoting blood and plasma donations.
KYB has a clear mission: to empower and educate the African/Caribbean community about blood disorders, encourage blood and plasma donations, and advocate for equitable access to healthcare resources and support services KYB serves as a vital voice for African/Caribbean people with blood disorders, promoting awareness and facilitating referrals to centers of excellence
KYB's initiatives would be comprehensive, focusing on multiple critical themes, including lived experiences, access to care, cultural barriers, patient-provider relationships, stigma, and mental health By partnering with other affiliates across Canada, KYB will collectively improve access to care and quality of life for individuals affected by blood disorders.
Promoting Blood Donation
KYB acknowledges the historical barriers that have contributed to health disparities and hesitancy around blood donation within the African/Caribbean community By fostering trust and promoting inclusivity, KYB will work to improve health outcomes and ensure a diverse and sufficient blood supply for all communities. Encouraging blood and plasma donations within the African/Caribbean community is a core objective for KYB. Only about 1% of Canadian blood donors are African/Caribbean, despite this group representing around 4-5% of the total population.
Increasing donations from these communities is crucial, as ethnicity can significantly impact the effectiveness of blood transfusions and treatments for certain illnesses. KYB aims to address historical mistrust and misconceptions about blood donation through targeted education and outreach programs.
Collaborative Efforts
KYB will collaborate extensively with healthcare providers, community organizations, government agencies, and stakeholders to leverage resources and expertise These partnerships will help to amplify KYB efforts in raising awareness, facilitating donations, and advocating for policy changes that support individuals with blood disorders For example, KYB intends to work with the Canadian Blood Services to conduct blood drives and raise awareness abo

Strategies and Goals
KYB has outlined clear strategies to achieve its mission:
1. Raise Awareness: KYB aims to raise awareness about various blood disorders through educational campaigns, community outreach, and online resources.
2. Promote Donation: KYB encourages blood and plasma donations from the African/Caribbean community by organizing blood drives and partnering with organizations
3. Provide Support: KYB offers support services and resources, including counselling and support groups for individuals and families affected by blood disorders
4. Advocate for Equity: KYB advocates for equitable access to healthcare services, treatments, and research opportunities
5. Collaborate and Partner: With healthcare providers, community organizations, and other stakeholders, KYB works to address blood disorders and promote health equity.
6 Measure Impact: KYB continuously monitors and evaluates the impact of its programs, collecting data on donation rates, community engagement, and health outcomes.
Community Engagement and Education
KYB engages the community through various events and workshops designed to educate and raise awareness These include:
Workshops and Seminars: Hosting educational sessions with guest speakers and healthcare professionals
Community Events: Participating in health fairs and festivals to connect with community members
Social Media Campaigns: Utilizing social media platforms to share information and engage with a broader audience
Healthcare Collaborations: Partnering with local healthcare providers to promote blood donations and offer free health screenings.
Join Us
KYB invites individuals, healthcare professionals, community leaders, and organizations to join this mission. Together, we can work towards reducing health disparities and improving outcomes for individuals with blood disorders in the African/Caribbean community. Whether through donating blood, volunteering, or simply spreading the word, every contribution helps create a healthier future
For more information on how you can get involved, send an email to knowyourblood2024@gmail.com or follow us on social media: Instagram: @Knowyourblood; TikTok: know.your.blood
Together, we can make a difference


C l i n i c a l T r i a l s a n d S u r v e y s






Care partners



Join My blood, My Health's Patient Advisory Council
Be part of the My blood, My Health Resource Advisory Council. Provide ongoing feedback on issues relevant to Patient Advocacy in Canada. We are looking for Patients, Care-partners, and General Advocates
Send you information to:
Admin@healcanada.org or visit our website and fill out our application form and find out more details about time commitment required.



Partners






My blood, My Health and Pat ADV Hub in the USA have embarked on a collaborative journey, aiming to revolutionize the realm of patient advocacy across North America. This pioneering partnership brings together two influential organizations from neighboring countries, combining theirextensiveexpertiseandresources.
The objective is to expand and enhance the access to critical information for patient advocates, ensuring that individuals across the continent receive the best possible support and guidance in theirhealthcarejourneys.
By bridging the gap between Canadian and American healthcare advocacy, this alliance promises to foster a more informed, empowered, and connected community of patient advocates, significantly contributing to the improvement of healthcare experiences for countlessindividuals.
email: patadvhub@gmail.com

www.patadvhub.org
My Blood, My Health Team
Brigitte Leonard, Ph.D

BrigitteLéonardistheChiefScientificOfficeratMyblood,My Health,aregisterednot-for-profitorganizationadvocating equitableaccesstoqualityhealthcareacrossCanada.Shehadthe privilegeofworkinginPharmaforover20years,contributingto bringinglife-changingtreatmentstopatientswiththehighest ethicalstandards.Now,shewantstoshareherknowledgeand utilizeherscientific,strategic,andcommunicationskillstohelpthe patients’community
SheobtainedherPh.D.inBiomedicalSciencesfrom Universitéde Montréalin2003.Herdoctoralresearchwasconductedunderthe supervisionofDr.Denis-ClaudeRoyatGuy-Bernier,MaisonneuveRosemontHospitalResearchCenter.Shedevelopedaquantitative diagnosticassayinnon-Hodgkin'slymphomaandevaluatedthe relevanceofthismarkerinthepatient'soutcome.
Cheryl Petruk, MBA B.Mgt.
CherylA.Petrukisamultifacetedprofessionalwhosecareerspans acrosspatientadvocacy,business,andpost-secondaryeducation, showcasingherdedicationtomakingasignificantimpactineach oftheseareas.

Cheryl'stransitionintopatientadvocacywasdrivenbyapassion fromherfamilycircumstancesandadeepcommitmentto ensuringpatients'rightsandaccesstocare.Cherylhasworked tirelesslytobridgethegapbetweenthehealthcaresystem, patients,andpharmastakeholders,ensuringthatpatients'voices areheardandtheirneedsaremet.Herworkinvolvescollaborating withStakeholdersandPatientAdvocacyOrganizations,lobbying forpatientcentricity,andprovidingpatientsupportandguidance.
Cheryl'sempatheticapproachanddedicationtoadvocacyhave madeherarespectedfigureinthisfield,admiredbypatients, healthcareprofessionals,andfellowadvocates
Cherylalsoleadsandistheleadfacultymemberat CACHEducation,PatientAdvocacyTraining.